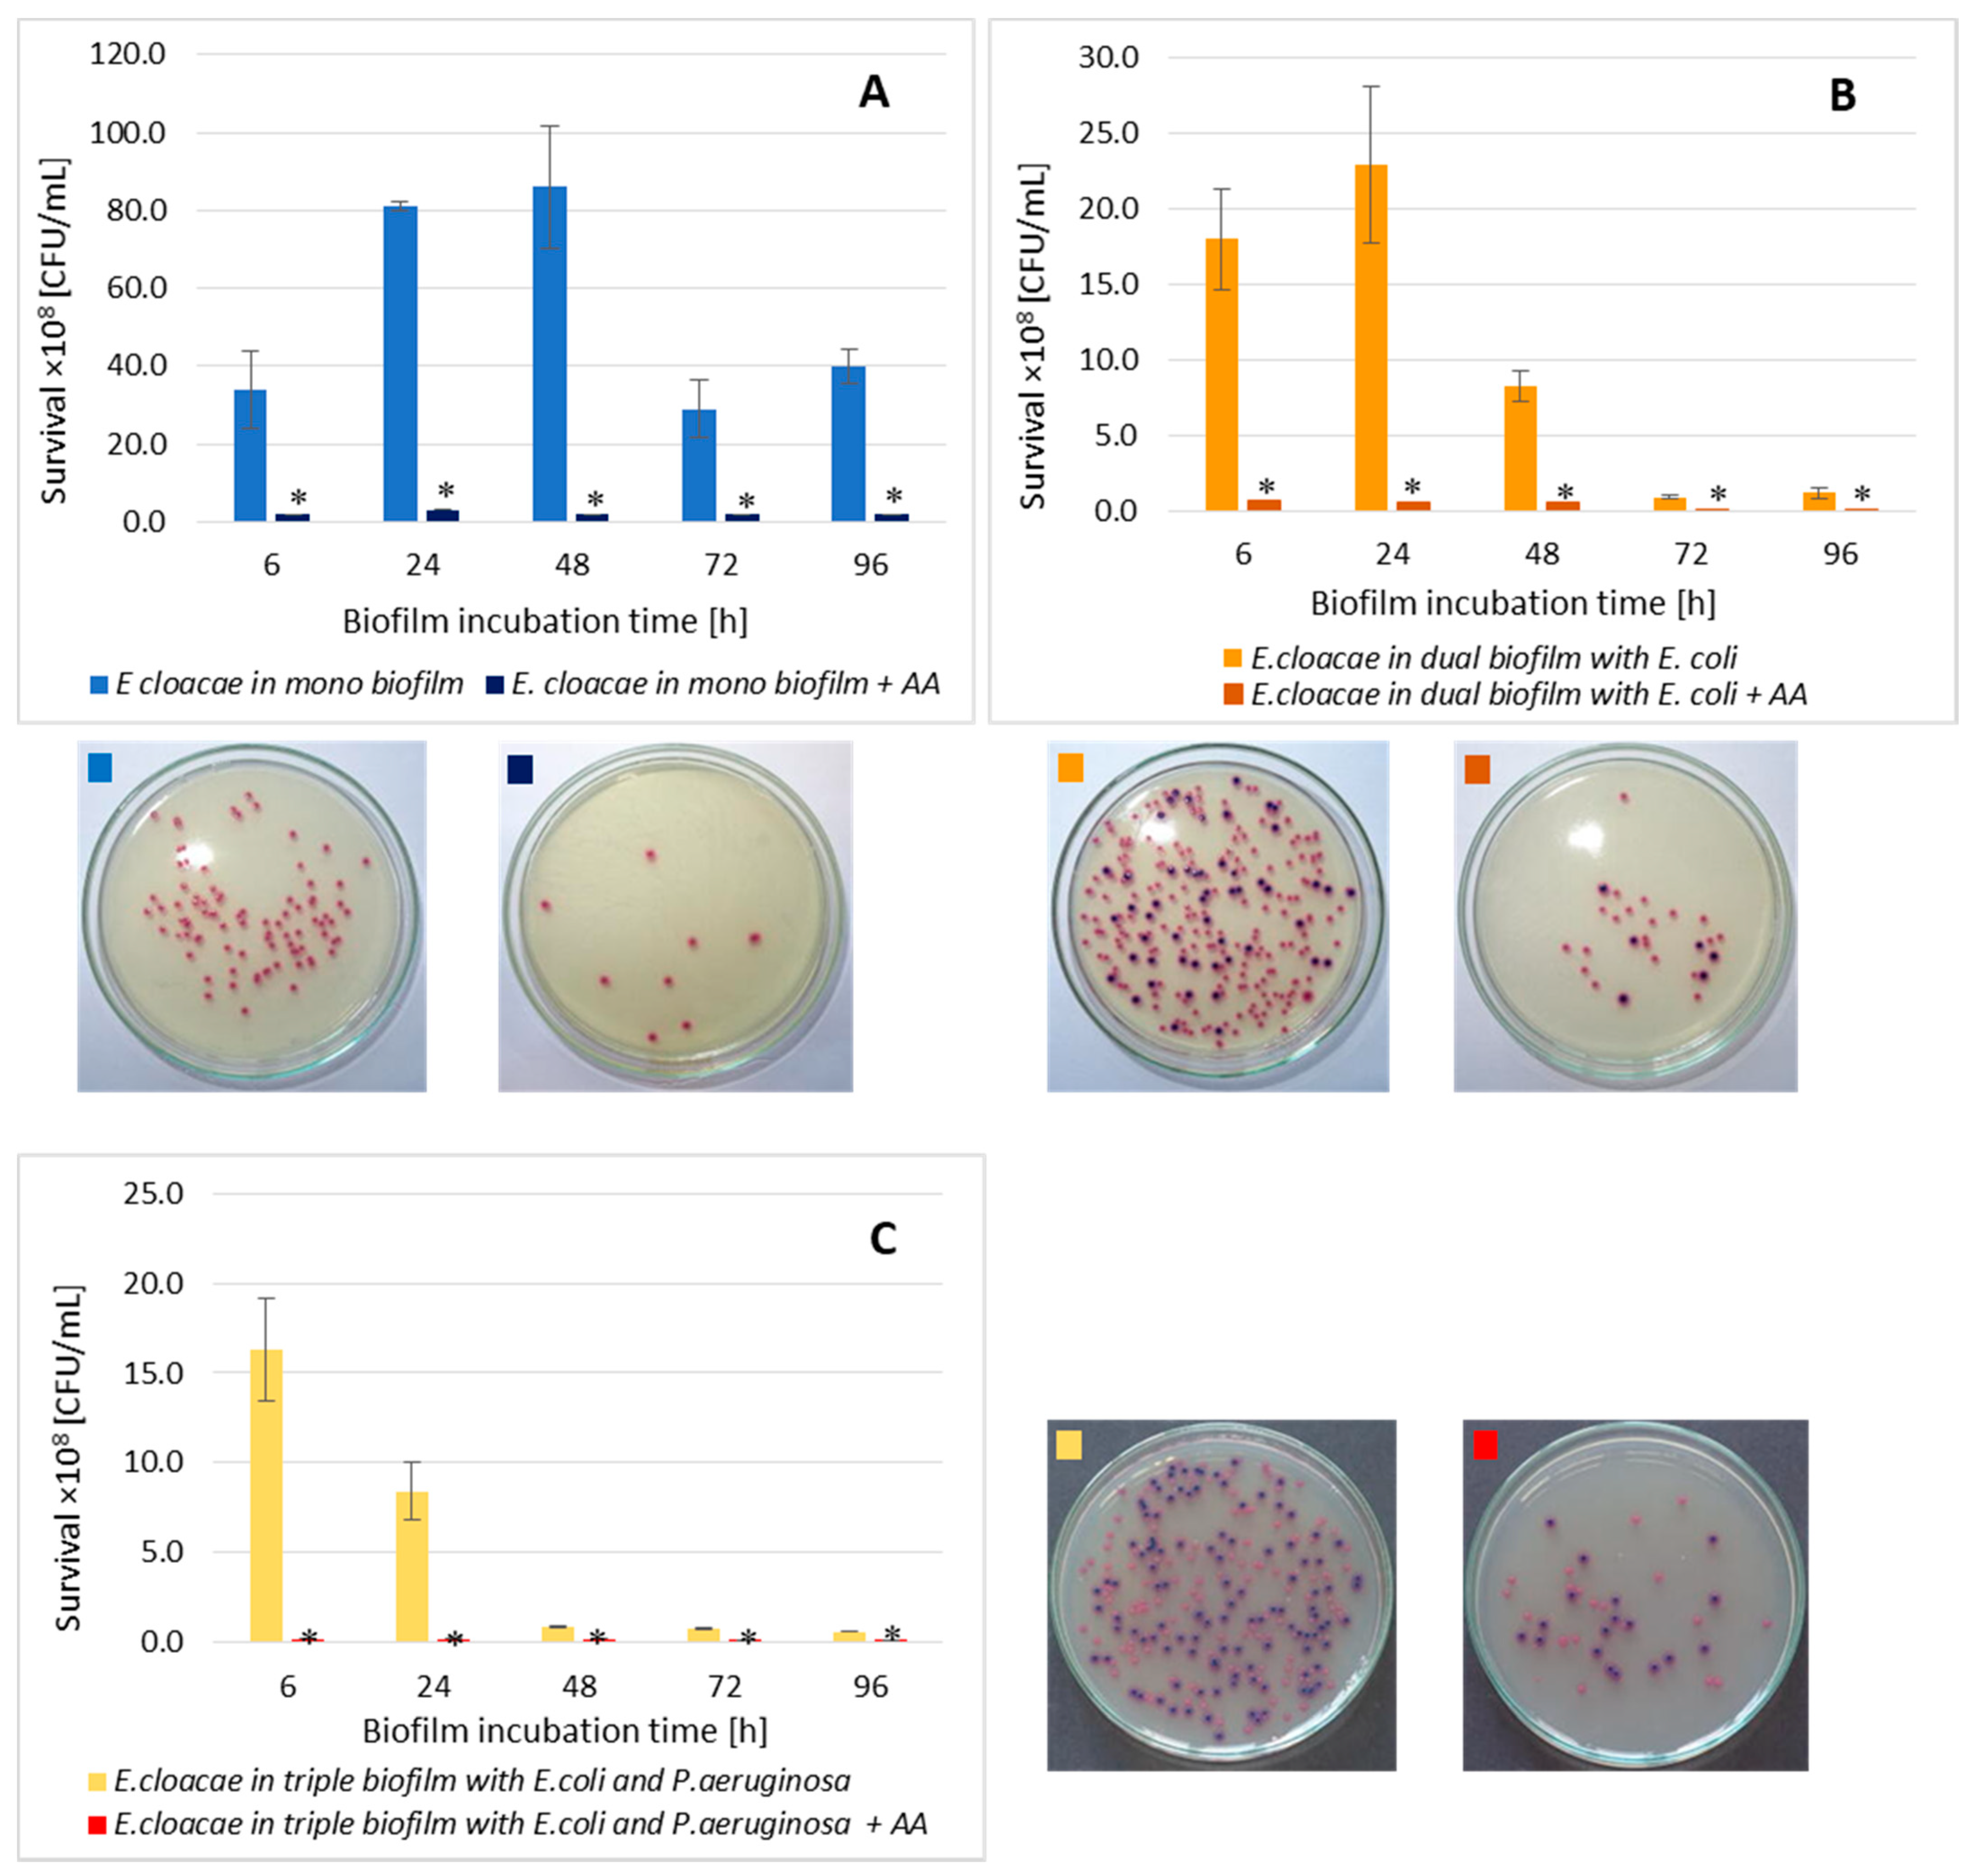
Biomolecules 11 01754 g009

Are Uropathogenic Bacteria Living in Multispecies Biofilm Susceptible to Active Plant Ingredient—Asiatic Acid?
Abstract
:1. Introduction
2. Materials and Methods
2.1. Bacterial Strains
2.2. Asiatic Acid
2.3. MIC (Minimal Inhibitory Concentration) and MBC (Minimal Bactericidal Concentration) Determination
2.4. Preparation of the Bacterial Suspension
2.5. Biofilm Cultures
2.6. The Bacterial Cell Count in Biofilm Cultures
2.7. Determination of the Biofilm Mass by Spectrophotometric Method
2.8. Determination of the Metabolic Activity of Bacteria in a Biofilm Using the Spectrophotometric Method
2.9. Effect of AA on Bacterial Cell Morphology
2.10. Statistical Analysis
3. Results and Discussion
3.1. MICs and MBCs Determination
3.2. The E. coli Cell Count in Mono-, Dual-, and Triple-Species Biofilms Untreated with AA
3.3. The E. cloacae Cell Count in Mono-, Dual- and Triple-Species Biofilms Untreated with AA
3.4. The P. aeruginosa Cell Count in Mono-, Dual- and Triple-Species Biofilms Untreated with AA
3.5. Formation of Biofilm Mass by Uropathogenic Rods in Mono-, Dual- and Triple-Species Biofilms Untreated with AA
3.6. Metabolic Activity of Uropathogenic Rods in Mono-, Dual- and Triple-Species Biofilms Untreated with AA
3.7. The E. coli Cell Count in Mono-, Dual-, and Triple-Species Biofilms Treated with AA
3.8. The E. cloacae Cell Count in Mono-, Dual-, and Triple-Species Biofilms Treated with AA
3.9. The P. aeruginosa Cell Count in Mono-, Dual-, and Triple-Species Biofilms Treated with AA
3.10. Formation of Biofilm Mass by Uropathogenic Rods in Mono-, Dual-, and Triple-Species Biofilms Treated with AA
3.11. Metabolic Activity of Uropathogenic Rods in Mono-, Dual-, and Triple-Species Biofilms Treated with AA
3.12. Effect of AA on Bacterial Morphology
4. Conclusions
Author Contributions
Funding
Institutional Review Board Statement
Informed Consent Statement
Data Availability Statement
Conflicts of Interest
References
- Lv, J.; Sharma, A.; Zhang, T.; Wu, Y.; Ding, X. Pharmacological review on asiatic acid and its derivatives: A potential compound. SLAS Technol. 2018, 23, 111–127. [Google Scholar] [CrossRef] [Green Version]
- Nagoor Meeran, M.F.; Goyal, S.N.; Suchal, K.; Sharma, C.; Patil, C.R.; Ojha, S.K. Pharmacological properties, molecular mechanisms, and pharmaceutical development of asiatic acid: A pentacyclic triterpenoid of therapeutic promise. Front. Pharmacol. 2018, 9, 892. [Google Scholar] [CrossRef] [PubMed]
- James, J.T.; Dubery, I.A. Pentacyclic triterpenoids from the medicinal herb, Centella asiatica (L.) Urban. Molecules 2009, 14, 3922–3941. [Google Scholar] [CrossRef] [PubMed] [Green Version]
- Jäger, S.; Trojan, H.; Kopp, T.; Laszczyk, M.N.; Scheffler, A. Pentacyclic triterpene distribution in various plants—Rich sources for a new group of multi-potent plant extracts. Molecules 2009, 14, 2016–2031. [Google Scholar] [CrossRef] [PubMed] [Green Version]
- Karłowicz-Bodalska, K.; Han, S.; Han, T.; Miranowicz, M.; Bodalska, A. Centella asiatica (L.) Urban, syn. Hydrocotyle asiatica L.– Asian pennywort—A famous medicinal plant of the Far East. Post. Fitoter. 2013, 4, 225–235. (In Polish) [Google Scholar]
- Sun, B.; Wu, L.; Wu, Y.; Zhang, C.; Qin, L.; Hayashi, M.; Kudo, M.; Gao, M.; Liu, T. Therapeutic potential of Centella asiatica and its triterpenes: A review. Front. Pharmacol. 2020, 11, 568032. [Google Scholar] [CrossRef]
- Thanusha, A.V.; Dinda, A.K.; Koul, V. Evaluation of nano hydrogel composite based on gelatin/HA/CS suffused with asiatic acid/ZnO and CuO nanoparticles for second degree burns. Mater. Sci. Eng. C Mater. Biol. Appl. 2018, 89, 378–386. [Google Scholar]
- Yuyun, X.; Xi, C.; Qing, Y.; Lin, X.; Ke, R.; Bingwei, S. Asiatic acid attenuates lipopolysaccharide-induced injury by suppressing activation of the Notch signaling pathway. Oncotarget 2018, 9, 15036–15046. [Google Scholar] [CrossRef] [PubMed]
- Han, Y.; Jiang, Y.; Li, Y.; Wang, M.; Fan, T.; Liu, M.; Ke, Q.; Xu, H.; Yi, Z. An aligned porous electrospun fibrous scaffold with embedded asiatic acid for accelerating diabetic wound healing. J. Mater. Chem. B. 2019, 7, 6125–6138. [Google Scholar] [CrossRef]
- Liew, K.Y.; Hafiz, M.F.; Chong, Y.J.; Harith, H.H.; Israf, D.A.; Tham, C.L. A review of malaysian herbal plants and their active constituents with potential therapeutic applications in sepsis. Evid. Based Complement. Alternat. Med. 2020, 2020, 8257817. [Google Scholar]
- Bylka, W.; Znajdek-Awizeń, P.; Studzińska-Sroka, E.; Dańczak-Pazdrowska, A.; Brzezińska, M. Centella asiatica in dermatology: An overview. Phytother Res. 2014, 28, 1117–1124. [Google Scholar] [CrossRef]
- Chandrika, U.G.; Prasad Kumarab, P.A. Gotu Kola (Centella asiatica): Nutritional properties and plausible health benefits. Adv. Food Nutr. Res. 2015, 76, 125–157. [Google Scholar]
- Djoukeng, J.D.; Abou-Mansour, E.; Tabacchi, R.; Tapondjou, A.L.; Bouda, H.; Lontsi, D. Antibacterial triterpenes from Syzygium guineense (Myrtaceae). J. Ethnopharmacol. 2005, 101, 283–286. [Google Scholar] [CrossRef] [Green Version]
- Acebey-Castellon, I.L.; Voutquenne-Nazabadioko, L.; Doan Thi Mai, H.; Roseau, N.; Bouthagane, N.; Muhammad, D.; Le Magrex Debar, E.; Gangloff, S.C.; Litaudon, M.; Sevenet, T.; et al. Triterpenoid saponins from Symplocos lancifolia. J. Nat. Prod. 2011, 74, 163–168. [Google Scholar] [CrossRef]
- Norzaharaini, M.G.; Wan Norshazwani, W.S.; Hasmah, A.; Nor Izani, N.J.; Rapeah, S. Preliminary study on antimicrobial activities of asiaticoside and asiatic acid against selected gram positive and gram-negative bacteria. Health Environ. J. 2011, 2, 23–26. [Google Scholar]
- Wong, K.C.; Hag Ali, D.M.; Boey, P.L. Chemical constituents and antibacterial activity of Melastoma malabathricum L. Nat. Prod. Res. 2012, 26, 609–618. [Google Scholar] [CrossRef]
- Wojnicz, D.; Kicia, M.; Tichaczek-Goska, D. Effect of asiatic and ursolic acids on morphology, hydrophobicity and adhesion of UPECs to uroepithelial cells. Folia Microbiol. 2013, 58, 245–252. [Google Scholar]
- Wojnicz, D.; Tichaczek-Goska, D.; Kicia, M. Effect of asiatic and ursolic acids on growth and virulence factors of uropathogenic Escherichia coli strains. Turk. J. Biol. 2013, 37, 556–564. [Google Scholar] [CrossRef]
- Liu, W.H.; Liu, T.C.; Mong, M.C. Antibacterial effects and action modes of asiatic acid. Biomedicine 2015, 5, 22–29. [Google Scholar] [CrossRef] [PubMed]
- Ashella, S.; Fleming, A.T. Antimicrobial activity of asiatic acid against bacteria and fungi. IJSR Online 2016, 5, 920–921. [Google Scholar]
- Wojnicz, D.; Tichaczek-Goska, D.; Korzekwa, K.; Kicia, M.; Hendrich, A. Anti-enterococcal activities of pentacyclic triterpenes. Adv. Clin. Exp. Med. 2017, 26, 483–490. [Google Scholar] [CrossRef] [PubMed]
- Harnvoravongchai, P.; Chankhamhaengdecha, S.; Ounjai, P.; Singhakaew, S.; Boonthaworn, K.; Janvilisri, T. Antimicrobial effect of asiatic acid against Clostridium difficile is associated with disruption of membrane permeability. Front. Microbiol. 2018, 9, 2125. [Google Scholar] [CrossRef] [PubMed]
- Garo, E.; Eldridge, G.R.; Goering, M.G.; DeLancey Pulcini, E.; Hamilton, M.A.; Costerton, J.W.; James, G.A. Asiatic acid and corosolic acid enhance the susceptibility of Pseudomonas aeruginosa biofilms to tobramycin. Antimicrob. Agents Chemother. 2007, 51, 1813–1817. [Google Scholar] [CrossRef] [PubMed] [Green Version]
- Wojnicz, D.; Tichaczek-Goska, D.; Kicia, M. Pentacyclic triterpenes combined with ciprofloxacin help to eradicate the biofilm formed in vitro by Escherichia coli. Indian J. Med. Res. 2015, 141, 343–353. [Google Scholar] [CrossRef] [Green Version]
- CLSI. Methods for Dilution Antimicrobial Susceptibility Test for Bacteria That Grow Aerobically, 11th ed.; CLSI standard M07; Clinical and Laboratory Standards Institut: Wayne, PA, USA, 2018. [Google Scholar]
- Di Bonaventura, G.; Spedicato, I.; D’Antonio, D.; Robuffo, I.; Piccolomini, R. Biofilm formation by Stenotrophomonas maltophilia modulation by quinolones, trimethoprim, sulfamethoxazole, and ceftazidime. Antimicrob. Agents Chemother. 2004, 48, 151–160. [Google Scholar] [CrossRef] [Green Version]
- O’Toole, G.A.; Kolter, R. Flagellar and twitching motility are necessary for Pseudomonas aeruginosa biofilm development. Mol. Microbiol. 1998, 30, 295–304. [Google Scholar] [CrossRef]
- Stepanović, S.; Vuković, D.; Hola, V.; Di Bonaventura, G.; Djukić, S.; Cirković, I.; Ruzicka, F. Quantification of biofilm in microtiter plates: Overview of testing conditions and practical recommendations for assessment of biofilm production by staphylococci. APMIS 2007, 115, 891–899. [Google Scholar] [CrossRef]
- Singh, A.K.; Prakash, P.; Achra, A.; Singh, G.P.; Das, A.; Singh, R.K. Standardization and classification of in vitro biofilm formation by clinical isolates of Staphylococcus aureus. J. Global. Infect. Dis. 2017, 9, 93–101. [Google Scholar]
- Kim, S.; Kim, M.J.; Kang, H.Y.; Seol, S.Y.; Cho, D.T.; Kim, J. A simple colorimetric method for testing antimicrobial susceptibility of biofilmed bacteria. J. Microbiol. 2010, 48, 709–711. [Google Scholar] [CrossRef]
- Haney, E.F.; Trimble, M.J.; Cheng, J.T.; Vallé, Q.; Hancock, R.E.W. Critical assessment of methods to quantify biofilm growth and evaluate antibiofilm activity of host defence peptides. Biomolecules 2018, 8, 29. [Google Scholar] [CrossRef] [Green Version]
- Taemchuay, D.; Rukkwamsuk, T.; Sakpuaram, T.; Ruangwises, N. Antibacterial activity of crude extracts of Centella asiatica against Staphylococcus aureus in bovine mastitis. Kasetsart Vet. 2009, 19, 119–128. [Google Scholar]
- Machado, I.; Lopes, S.P.; Sousa, A.M.; Pereira, M.O. Adaptive response of single and binary Pseudomonas aeruginosa and Escherichia coli biofilms to benzalkonium chloride. J. Basic Microbiol. 2012, 52, 43–52. [Google Scholar] [CrossRef] [Green Version]
- Vanysacker, L.; Denis, C.; Declerck, P.; Piasecka, A.; Vankelecom, I.F. Microbial adhesion and biofilm formation on microfiltration membranes: A detailed characterization using model organisms with increasing complexity. Biomed. Res. Int. 2013, 2013, 470867. [Google Scholar] [CrossRef] [PubMed]
- Cerqueira, L.; Oliveira, J.A.; Nicolau, A.; Azevedo, N.F.; Vieira, M.J. Biofilm formation with mixed cultures of Pseudomonas aeruginosa/Escherichia coli on silicone using artificial urine to mimic urinary catheters. Biofouling 2013, 29, 829–840. [Google Scholar] [CrossRef] [PubMed]
- Kuznetsova, M.V.; Maslennikova, I.L.; Karpunina, T.I.; Nesterova, L.Y.; Demakov, V.A. Interactions of Pseudomonas aeruginosa in predominant biofilm or planktonic forms of existence in mixed culture with Escherichia coli in vitro. Can. J. Microbiol. 2013, 59, 604–610. [Google Scholar] [CrossRef]
- Oliveira, A.; Sousa, J.C.; Silva, A.C.; Melo, L.D.R.; Sillankorva, S. Chestnut honey and bacteriophage application to control Pseudomonas aeruginosa and Escherichia coli biofilms: Evaluation in an ex vivo wound model. Front. Microbiol. 2018, 9, 1725. [Google Scholar] [CrossRef] [PubMed] [Green Version]
- Solis-Velazquez, O.A.; Gutiérrez-Lomelí, M.; Guerreo-Medina, P.J.; Rosas-García, M.L.; Iñiguez-Moreno, M.; Avila-Novoa, M.G. Nosocomial pathogen biofilms on biomaterials: Different growth medium conditions and components of biofilms produced in vitro. J. Microbiol. Immunol. Infect. 2020. [Google Scholar] [CrossRef]
- Mirani, Z.A.; Fatima, A.; Urooj, S.; Aziz, M.; Khan, M.N.; Abbas, T. Relationship of cell surface hydrophobicity with biofilm formation and growth rate: A study on Pseudomonas aeruginosa, Staphylococcus aureus, and Escherichia coli. Iran J. Basic Med. Sci. 2018, 21, 760–769. [Google Scholar]
- Davies, D.G.; Marques, C.N.H. A fatty acid messenger is responsible for inducing dispersion in microbial biofilms. J. Bacteriol. 2009, 191, 1393–1403. [Google Scholar] [CrossRef] [Green Version]
- Rahmani-Badi, A.; Sepehr, S.; Mohammadi, P.; Soudi, M.R.; Babaie-Naiej, H.; Fallahi, H. A combination of cis-2-decenoic acid and antibiotics eradicates pre-established catheter-associated biofilms. J. Med. Microbiol. 2014, 63, 1509–1516. [Google Scholar] [CrossRef]
- Tiwari, R.; Karthik, K.; Rana, R.; Malik, Y.S.; Dhama, K.; Joshi, S.K. Quorum sensing inhibitors/antagonists countering food spoilage bacteria-need molecular and pharmaceutical intervention for protecting current issues of food safety. Int. J. Pharmacol. 2016, 12, 262–271. [Google Scholar] [CrossRef]
- Cao, T.; Morales-Soto, N.; Jia, J.; Baig, N.F.; Dunham, S.J.B.; Ellis, J.; Sweedler, J.V.; Shrout, J.D.; Bohn, P.W. Spatiotemporal dynamics of molecular messaging in bacterial co-cultures studied by multimodal chemical imaging. Proc. SPIE Int. Soc. Opt. Eng. 2019, 10863, 108630A. [Google Scholar] [PubMed]
- Bhattacharjee, A.; Khan, M.; Kleiman, M.; Hochbaum, A.I. Effects of growth surface topography on bacterial signaling in coculture biofilms. ACS Appl. Mater. Interfaces 2017, 9, 18531–18539. [Google Scholar] [CrossRef] [PubMed]
- Chu, W.; Zere, T.R.; Weber, M.M.; Wood, T.K.; Whiteley, M.; Hidalgo-Romano, B.; Valenzuela, E., Jr.; McLean, R.J. Indole production promotes Escherichia coli mixed-culture growth with Pseudomonas aeruginosa by inhibiting quorum signaling. Appl. Environ. Microbiol. 2012, 78, 411–419. [Google Scholar] [CrossRef] [Green Version]
- Lopes, S.P.; Machado, I.; Pereira, M.O. Role of planktonic and sessile extracellular metabolic byproducts on Pseudomonas aeruginosa and Escherichia coli intra and interspecies relationships. J. Ind. Microbiol. Biotechnol. 2011, 38, 133–140. [Google Scholar] [CrossRef] [Green Version]
- Castonguay, M.H.; van der Schaaf, S.; Koester, W.; Krooneman, J.; van der Meer, W.; Harmsen, H.; Landini, P. Biofilm formation by Escherichia coli is stimulated by synergistic interactions and co-adhesion mechanisms with adherence-proficient bacteria. Res. Microbiol. 2006, 157, 471–478. [Google Scholar] [CrossRef]
- Wang, X.; Lünsdorf, H.; Ehrén, I.; Brauner, A.; Römling, U. Characteristics of biofilms from urinary tract catheters and presence of biofilm-related components in Escherichia coli. Curr. Microbiol. 2010, 60, 446–453. [Google Scholar] [CrossRef]
- Qian, W.; Fu, Y.; Liu, M.; Zhang, J.; Wang, W.; Li, J.; Zeng, Q.; Wang, T.; Li, Y. Mechanisms of action of luteolin against single- and dual-species of Escherichia coli and Enterobacter cloacae and its antibiofilm activities. Appl. Biochem. Biotechnol. 2021, 193, 1397–1414. [Google Scholar] [CrossRef]
- Liu, N.T.; Nou, X.; Lefcourt, A.M.; Shelton, D.R.; Lo, Y.M. Dual-species biofilm formation by Escherichia coli O157:H7 and environmental bacteria isolated from fresh-cut processing facilities. Int. J. Food Microbiol. 2014, 171, 15–20. [Google Scholar] [CrossRef]
- Culotti, A.; Packman, A.I. Pseudomonas aeruginosa promotes Escherichia coli biofilm formation in nutrient-limited medium. PLoS ONE 2014, 9, e107186. [Google Scholar] [CrossRef]
- Bharitkar, Y.P.; Banerjee, M.; Kumar, S.; Paira, R.; Meda, R.; Kuotsu, K.; Mondal, N.B. Search for a potent microbicidal spermicide from the isolates of Shorea robusta resin. Contraception 2013, 88, 133–140. [Google Scholar] [CrossRef] [PubMed]
- Schwering, M.; Song, J.; Louie, M.; Turner, R.J.; Ceri, H. Multi-species biofilms defined from drinking water microorganisms provide increased protection against chlorine disinfection. Biofouling 2013, 29, 917–928. [Google Scholar] [CrossRef] [PubMed]
- Nostro, A.; Scaffaro, R.; D’Arrigo, M.; Botta, L.; Filocamo, A.; Marino, A.; Bisignano, G. Development and characterization of essential oil component-based polymer films: A potential approach to reduce bacterial biofilm. Appl. Microbiol. Biotechnol. 2013, 97, 9515–9523. [Google Scholar] [CrossRef] [PubMed]
- Kong, K.F.; Schneper, L.; Mathee, K. Beta-lactam antibiotics: From antibiosis to resistance and bacteriology. APMIS 2010, 118, 1–36. [Google Scholar] [CrossRef] [PubMed] [Green Version]
- El-Hajj, Z.W.; Newman, E.B. How much territory can a single E. coli cell control? Front. Microbiol. 2015, 6, 309. [Google Scholar] [CrossRef]
- Justice, S.S.; Hunstad, D.A.; Seed, P.C.; Hultgren, S.J. Filamentation by Escherichia coli subverts innate defenses during urinary tract infection. Proc. Natl. Acad. Sci. USA 2006, 103, 19884–19889. [Google Scholar] [CrossRef] [Green Version]
- Cheng, G.; Hao, H.; Dai, M.; Liu, Z.; Yuan, Z. Antibacterial action of quinolones: From target to network. Eur. J. Med. Chem. 2013, 66, 555–562. [Google Scholar] [CrossRef]
- Cushnie, T.P.; O’Driscoll, N.H.; Lamb, A.J. Morphological and ultrastructural changes in bacterial cells as an indicator of antibacterial mechanism of action. Cell. Mol. Life Sci. 2016, 73, 4471–4492. [Google Scholar] [CrossRef]

| E. coli CFT073 | E. cloacae BAA2468 | P. aeruginosa ATCC 25000 | ||
|---|---|---|---|---|
| AA concentration (µg/mL) | MIC | 1536 | 1024 | 1536 |
| MBC | 2048 | 1536 | 2048 |
Publisher’s Note: MDPI stays neutral with regard to jurisdictional claims in published maps and institutional affiliations. |
© 2021 by the authors. Licensee MDPI, Basel, Switzerland. This article is an open access article distributed under the terms and conditions of the Creative Commons Attribution (CC BY) license (https://creativecommons.org/licenses/by/4.0/).
Share and Cite
Sycz, Z.; Tichaczek-Goska, D.; Jezierska-Domaradzka, A.; Wojnicz, D. Are Uropathogenic Bacteria Living in Multispecies Biofilm Susceptible to Active Plant Ingredient—Asiatic Acid? Biomolecules 2021, 11, 1754. https://doi.org/10.3390/biom11121754
Sycz Z, Tichaczek-Goska D, Jezierska-Domaradzka A, Wojnicz D. Are Uropathogenic Bacteria Living in Multispecies Biofilm Susceptible to Active Plant Ingredient—Asiatic Acid? Biomolecules. 2021; 11(12):1754. https://doi.org/10.3390/biom11121754
Chicago/Turabian StyleSycz, Zuzanna, Dorota Tichaczek-Goska, Anna Jezierska-Domaradzka, and Dorota Wojnicz. 2021. "Are Uropathogenic Bacteria Living in Multispecies Biofilm Susceptible to Active Plant Ingredient—Asiatic Acid?" Biomolecules 11, no. 12: 1754. https://doi.org/10.3390/biom11121754
APA StyleSycz, Z., Tichaczek-Goska, D., Jezierska-Domaradzka, A., & Wojnicz, D. (2021). Are Uropathogenic Bacteria Living in Multispecies Biofilm Susceptible to Active Plant Ingredient—Asiatic Acid? Biomolecules, 11(12), 1754. https://doi.org/10.3390/biom11121754






